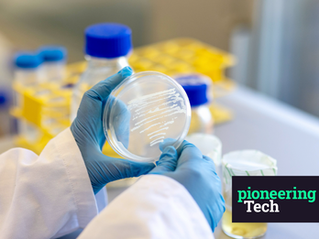
The Building Material that Grows in a Lab

our mission
What if compostable alternatives simply performed better?
Every year, over 400 million tons of oil-based plastics are produced and nearly all of it accumulates in landfills, oceans, and ecosystems for centuries. These materials were never designed with an end-of-life in mind.
At Foamlab, we are building a different future: one where materials are grown, not extracted. Our mission is to replace pollutive plastics with high-performance, compostable alternatives that outperform the status quo.

Our journey began with groundbreaking research at Delft University of Technology, where we discovered the transformative potential of
bio-nanocellulose, a naturally occurring biomaterial with exceptional strength, purity, and adaptability. It is often described as “a platform for materials”.
This discovery sparked a vision: to reimagine plastics and foam-like materials from the cell up, using biology as a tool for systemic change.
Sustainability should not be a compromise, it should be an upgrade.
our materials
Nature-grown.
Performance-tuned.
At the heart of Foamlab is our bio-nanocellulose foam, cultivated by microorganisms through a fermentation process.
Thanks to its highly porous, nanofibrillar structure, our foam feels nearly weightless, while still delivering strength and durability.


But it’s not one-size-fits-all. Through precise control over our microbial fermentation and drying process, we can tune the density of the foam to suit different performance needs: from ultra-lightweight applications where minimal mass is critical, to denser variants for more structural or impact-resistant uses.

Our foams can have various levels of softness and compressibility. Some of our foams compress easily under touch, like a natural sponge. Others resist pressure and retain their shape, behaving more like polystyrene or dense cork.
We can grow foams that twist, fold, or wrap without tearing. On the other end, we also develop rigid foams with high dimensional stability for load-bearing, form-retaining structures, similar to wood-based foam or molded fiber.


We can mold the foam into complex 3D forms with clean edges and fine resolution, or we can dry it and ground into powder or beads. Also, we coat objects, like pipes, with our foam.
All of this tunability is achieved without synthetic binders, crosslinkers, or petrochemical inputs: just careful control of microbial growth and post-processing.
from lab to market
Each variant of our bio-nanocellulose foam is developed with end-use in mind.
From protective packaging and insulation to textiles and fashion accessories, our materials offer circularity by design: bio-based, compostable, and produced with minimal environmental impact.
We do not just grow materials.
We grow solutions.
insulation
furniture
aviation & automotive
thermal packaging
textiles & footwear
cosmetics
why foamlab's nano materials
Biology at the nanoscale. Performance at every level.
What sets Foamlab apart is our control over structure at the nanoscale, made possible by microbial biofabrication. This allows us to fine-tune mechanical, acoustic, and aesthetic properties with precision — all while maintaining biodegradability and low-impact production.

high insulation efficiency

high purity

ultra-lightweight

biocompatibility

high mechanical performance

compostability
our team
We are an interdisciplinary team bringing together backgrounds in biology, engineering, product development, and sustainability.
Our motto: material innovation that works with nature.
Not against it.

Scientific advisor
& Co-Founder

CEO
& Co-Founder

Process Design Engineer

Senior Scientist

Research Scientist

Polymer Scientist

Product Manager
Foamlab is growing, just like our materials.
We are looking for curious minds who are passionate about biotech, circular design, and regenerative material innovation.
news & updates
let's connect
Whether you are exploring sustainable materials for your product line or looking to co-develop a custom solution, we woud love to hear from you.
careers
We are seeking a highly skilled and motivated PhD/MSc+ in Microbiology with expertise in bacterial cellulose production and optimization, and bioprocess development. The ideal candidate will contribute to research and development efforts aimed at improving bacterial cellulose yield, quality, and scalability for various industrial applications.
Read the full job description here